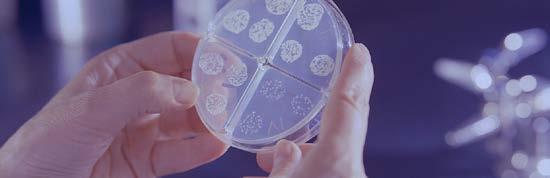

SCIENCE

90 Seconds Till Midnight : Doomsday Clock

Triston Wong
TECHNOLOGY
Chat GPT

Chanyeong Park
ENGINEERING
Control Systems in Robotics
Marcus Chin
MATHEMATICS
Golden Ratio
Sophia Reiner
VOL.3 2023 MAY
SCIENCE · TECHNOLOGY · ENGINEERING · MATHEMATICS MAGAZINE 01
EDITOR TEAM
Editor in Chief
Gyulim Jessica Kang (11)
Vice Editors in Chief
Shreya Srivastava (12)
Sophia Reiner (11)
Section Editors
Chanyeong Park (12)
Nikita Chanda (11)
Akshay Agarwal (10)
Outreach Officers
Ashley Han (11)
Yil-lin Jeon (11)
Editors
Utsa Chaturvedi (12)

Marcus Chin (11)
Lauren Lim (11)
Aaron Brest (11)
Daniel Ng (11)
Rohan Agrawal (11)
Morgan Ahn (11)
Vyjayanti Vasudevan (10)
Alanna Hattori (9)
DESIGN TEAM
Team Leader
Seohyun Lee (11)
Members
Ashley Lan (11)
Hyeonseo Kwon (11)
Yuku Kasanagi (10)
Azara Mathur (9)
Avi Saha (9)
Note From the Editor-in-Chief
Gyulim Jessica Kang

Welcome to the third volume of Spectrum Magazine! This semester, our team has been working hard to curate an issue filled with informative and engaging STEM content, covering a diverse range of topics from the latest breakthroughs in neuroscience to cutting-edge research in artificial intelligence. In this issue, we’re excited to spotlight our new STEM mentorship program with the elementary students, headed by outreach officers Ashley and Yil-lin with the elementary students. Read on to find out more about the program’s origins and impact!
As always, we’d like to thank our teacher sponsor, Ms. Herzman, for her support, and our talented team of editors and designers for their unwavering dedication. To our readers, we value your feedback and ideas for future issues. Thank you for your continued support, and have fun reading!
03
CONTENTS
SCIENCE & MATHEMATICS
Marriage, School Choice, Class Assignments, Galore: Matching Mechanisms
Gyulim Jessica Kang
The Golden Ratio: The History, Existence, and Application

Sophia Reiner Game Theory
Akshay Agarwal
Glia: The Lesser Known Brain Cells
Lauren Lim
Dumb Ways to Die: Earth Edition
Shreya Srivastava
The Microbiome Revolution: Unlocking its Full Potential for Improved Health
Daniel Ng
90 Seconds Till Midnight
Triston Wong
DNA Data Storage
Irene Choi
Coronary Artery Disease and its Treatment
Morgan Ahn
The Psychological Effect of Stress on Performance and Learning Memory
Anna Hyunjin Choi
How does Anorexia Impact the Brain?
Alanna Hattori
How does the Sun keep Shining?
Nikita Chanda
SPECTRUM VOL.3
TECHNOLOGY & ENGINEERING
An Introduction to Lethal Autonomous Weapons Systems (LAWS)
Vyjayanti Vasudevan
ChatGPT
Chan Park
Control Systems in Robotics
Marcus Chin
COMMUNITY
Introducing the Spectrum STEM
Gyulim Jessica Kang

05
2023 MAY
The

Akshay
Glia:
SCIENCE & MATHEMATICS 08 12 18 22 26 Marriage, School Choice, Class Assignments, Galore: Matching Mechanisms Gyulim Jessica Kang
Golden Ratio: The History, Existence, and Application
Reiner
Theory
Sophia
Game
Agarwal
Lesser Known Brain
Lauren Lim
Ways to Die: Earth Edition Shreya Srivastava The Microbiome Revolution: Unlocking its Full Potential for Improved Health Daniel Ng 90 Seconds Till Midnight: Doomsday Clock Triston Wong 30 34
The
Cells
Dumb

DNA Data Storage Irene Choi 38 Coronary Artery Disease and its Treatment Morgan Ahn The Psychological Effect of Stress on Performance and Learning Memory Anna Hyunjin Choi 42 48 How does Anorexia Impact the Brain? Alanna Hattori 54 How does the Sun Keep Shining? Nikita Chanda 58
Marriage, School Choice, Class Assignments, Galore: Matching Mechanisms
 By Gyulim Jessica Kang
By Gyulim Jessica Kang
MATHEMATICS
Photo by Brooke Cagle on Unsplash
Thisquestion was originally proposed and answered by Gale and Shapley in 1962; since then, the solutions to the variants of the question have been applied to school choice, medical residency matching, and the assignment of cadets to military branches. Gale and Shapley tried to find a one-to-one stable matching (a set of pairings in which (1) all men and women find their partners acceptable and (2) no man/woman pair prefers each other to their assigned partners. By a process called the deferred acceptance algorithm, Gale and Shapley proved that a stable matching exists for any finite set of men and women and their preferences. The algorithm is described as follows:
1. Each man proposes to his most preferred woman. Each woman selects her most preferred man out of those who proposed to her and puts him on her waiting list; the rest are rejected.
2. Each man that was rejected proposes to his next preferred woman. Each woman selects her most preferred man among those that proposed to her, including the man on the waiting list.
3. Repeat Step 2 until no men who are available to propose are left.
Marriage, School Choice, Class Assignments, Galore: Matching Mechanisms
For example, consider the following situation with 5 men and 4 women:
P(m ) denotes the preference relation of m : for instance, m5 prefers w1 over w2, w2 over w4, and w4 over staying single. m5 would rather stay single than be matched with w3 or w5. Assume that the preferences of the women are as follows:

If we apply the deferred acceptance algorithm to this specific example,
1) m1, m4, and m5 propose to w1, who only holds m1; m2 and m3 propose to w4, who only holds m2. This yields a tentative matching

i i
09
Given a set of men and women whose preferences are in the opposite gender, how should we form pairs such that no agent has the incentive to rematch?
2) m3 , m4 , and m5 propose to w3 , w4 , and w2 ,respectively; w4 rejects m2 and holds m4 . The tentative matching is thus revised to


Pareto-Optimality
A stable matching is Pareto-optimal if there is no other matching that makes some agents better off without making anyone worse off.
Strategy-Proofness
A matching mechanism is strategy-proof if each agent has a dominant strategy of truthfully reporting his/her preference.
3) m2 proposes to w2, who rejects m5 and holds m2. The tentative matching is thus revised to


4) m5 proposes to w4, who rejects m5 and holds m4,which stops the procedure and results in Stableness
A stable matching is a matching where no pair of agents would mutually prefer to be matched to each other than to their assigned partners.
In the economic theory of two-sided many-to-one matching, a particular problem of interest is the mechanism of school assignment. Ever since the deferred acceptance algorithm was first proposed by Gale and Shapley (1962), there has been much research about mechanisms that optimally match students to schools in real-world situations. Applications of matchings in school choice have been made to mimic real-life scenarios. Ehlers, Hafalir, Yenmez, and Yildirim studied controlled choice over public schools; Benabbou, Chakraborty, Ho, Sliwinski, and Zick investigated the impact of diversity constraints on public housing allocation. Pathak and Sönmez compared various mechanisms by their susceptibility to manipulation.
In 1962, Gale and Shapley proposed a solution to the problem of pairing men and women in stable relationships.

SPECTRUM 10 SPECTRUM VOL.3 MATHEMATICS
Marriage, School Choice, Class Assignments, Galore: Matching Mechanisms

References
Gale, D., & Shapley, L. S. (1962). College admissions and the stability of marriage. The American Mathematical Monthly, 69(1), 9-15.
Abdulkadiroğlu, A., & Sönmez, T. (2003). School choice: A mechanism design approach. American economic review, 93(3), 729-747.
Roth, A. E., & Sotomayor, M. (1992). Two-sided matching. Handbook of game theory with economic applications, 1, 485-541.
Sönmez, T., & Switzer, T. B. (2013). Matching with (branch‐of‐choice) contracts at the United States Military Academy. Econometrica, 81(2), 451-488.
Ehlers, L., Hafalir, I. E., Yenmez, M. B., & Yildirim, M. A. (2014). School choice with controlled choice constraints: Hard bounds versus soft bounds. Journal of Economic theory, 153, 648-683.
Benabbou, N., Chakraborty, M., Ho, X. V., Sliwinski, J., & Zick, Y. (2018, July). Diversity constraints in public housing allocation. In 17th International Conference on Autonomous Agents and MultiAgent Systems (AAMAS 2018).
Pathak, P. A., & Sönmez, T. (2013). School admissions reform in Chicago and England: Comparing mechanisms by their vulnerability to manipulation. American Economic Review, 103(1), 80-106.
Their solution, called the deferred acceptance algorithm, has since been applied to various real-world situations such as school choice and medical residency matching.
Researchers continue to study and improve upon this algorithm to find the best way to match students to schools. The work of Gale and Shapley continues to be an important area of study in the field of matching.
11
Photo by Giulia Squillace on Unsplash
The Golden Ratio: The History, Existence, and Application
 By Sophia Reiner
Photo by Giulia May on Unsplash
By Sophia Reiner
Photo by Giulia May on Unsplash
Introduction
Whatdo flower petals, shells, and societally decided beautiful faces have in common? They fit the golden ratio. The golden ratio, also known as the Divine Ratio and Phi (φ), is a mathematical ratio existent throughout the universe. Labelled by astrophysicist Mario Livio, the golden ratio “provides us with an intriguing mingling” of the definitions of proportion “that, while defined mathematically, it is claimed to have pleasingly harmonious qualities.”
However, to break this down, Euclid –the ancient Greek mathematician – told the golden ratio to be demonstrated when “the whole line is to the greater segment, so is the greater to the lesser.” What this means is that if the line below is used as an example, if the ratio of length AC is to CB the same as AB to AC, then this demonstrates the golden ratio (Livio, 2002).
When mathematically put, the proportions of AC/AB = AB/CB cross multiplied becomes x² – x – 1; this then creates the solutions of (1+√5)/2 and (1-√5)/2. The golden ratio Phi is the only number where the following can occur: “φ*φ'=-1 where φ' is the negative solution to the quadratic (1√5)/2” (Fett, 2006; Huntley, 1970).

Geometrically, the image below – the Golden Spiral – is a logarithmic spiral with a growth factor of the golden ratio.

The golden ratio can further be quantified in the Fibonacci sequence, in which as the numbers increase, the ratio between each pair of numbers gets closer to the golden ratio (or 1.618033988749895). The Fibonacci sequence which can start with 0 or 1 follows the following sequence:
55, 89, 144…. ∞
The formula for this is as follows:
Overall, this phenomenon of the golden ratio, golden spiral, and Fibonacci sequence is relevant in human biology, desired human characteristics, and throughout nature.
The Golden Ratio in Human Biology
The golden ratio is found through the
The Golden Ratio: The History, Existence, and Application
1, 1, 2, 3, 5, 8, 13, 21,
34,
13
human body, such as in clenched fists, the human skull, and the heart – despite being less widely discussed. For instance, Dr. William Littler in 1973 proposed that a clenched fist can demonstrate approximately the Golden Spiral (Figure 1) (Persaud, 2015).

In regards to skull shapes, Johns Hopkins researchers Rafael Tamargo and Jonathan Pindrik identified that the dimensions of human skulls, in comparison to other animals’ skulls, display the golden ratio.
ventricle and left atrium), the angles between the “mid-luminal axes of the pulmonary trunk and the ascending aortic continuation,” and also between the “outflow tract axis and continuation of the inflow tract axis of the right ventricle” demonstrate this golden ratio (Henein et al., 2011).
In short, Littler, Tamargo, Pindrik, and Henein support the findings that the golden ratio is naturally apparent all around the body – in bones and organs (including sensory organs).
The Golden Ratio in Surgical Interventions
Dr Michael Henein and colleagues of Sweden’s Umea University have found the golden ratio in the hearts as well. In both healthy individuals as well as those with mild heart failure, parts of the heart – vertical and transverse dimensions – fulfill the golden ratio regardless of ethnically influenced dimensions. Furthermore, healthy ventricles’ mitral annulus (the junction between the
Beyond the golden ratio being found throughout human biology, society has led individuals to further desire the golden ratio to be illustrated within physical characteristics. Golden ratio proportions have been consistently proposed as a method of “defin[ing] anatomical beauty” – with it being “commonly accepted that facial beauty correlates with anatomical symmetry” (Persaud, 2015; Rhodes et al., 1998). In dentistry for instance, Levin (1978) found the width of the maxillary central incisor and the width of the lateral incisor create the golden ratio proportion, as do the width of the maxillary lateral incisor with the width of the canine. This inspired later research on this golden proportion to identify the appropriate spacing of teeth, which then informed treatment; despite this, the application in creating the perfect smile has recently been questioned.
SPECTRUM 14 SPECTRUM VOL.3 MATHEMATICS
Furthermore, plastic surgery has focused on utilising the golden ratio to create ‘perfection.’ A few examples of creating this facial symmetry through cosmetic surgery include implementing the golden ratio into the ratios between the mouth and nose widths, space in the middle of each eyebrow and eyeball, and lower lip and upper lip widths (Inanli, 2021). To analyse another instance more indepth, in abdominoplasties (known informally as a tummy tuck), the golden ratio is taken advantage of to get the goal proportion between the perimeter of the waist and the hips (Hwang & Park, 2021). Dr. Giuseppe Visconti and colleagues created a survey which presented participants with pictures of varying navel shapes and positions, in which most participants identified the photos in which the navel was moved based on the golden ratio as the most attractive –concluding that the most aesthetically attractive naval position to be at the “xiphoid-umbilicus:umbilicus-abdominal crease golden ratio.”
In essence, researchers’ continued studies on the long-lasting topic of the golden ratio in humans have identified certain fields in which societal perceptions have also grown in favour of golden ratio proportions and thus influencing surgical interventions.
The Golden Ratio: The History, Existence, and Application
The Golden Ratio Elsewhere
However, the role of the golden ratio has further significance in other fields – for instance, where it is most recognisable: nature. The following are natural examples that exclude human characteristics:
- Contour spirals of shells
- Ram horns
- Elephant tusks
- Flower petals
- DNA molecules
- Spiral galaxies
Other fields such as investing employ the golden ratio, in which traders and technical analysts use the ratio to predict changes to market-driven prices. To expand, technical analysis works to identify the trading signals and price patterns of past investment data to forecast future movement. While the efficacy of technical analysis is frequently debated, the golden ratio is used to identify instances of herd behaviour (Kuepper, 2022). Essentially, the golden ratio in the form of the Fibonacci sequence is converted into percentages (38.2%, 50%, and 61.8% to “estimat[e] areas of support and resistance” in the analysis of price positions for a more accurate prediction (Kuepper, 2022).
In general, the natural occurrence of the golden ratio in life is found in many existing spirals – both living and dead! 15 15
Conclusion
In conclusion, the extensive research (both historically and in the present day) on the golden ratio demonstrates its relevance not only in naturally existing life, society’s desired traits, but also in investment analysis. This implies the significance of mathematical phenomena throughout society and in understanding the mechanisms behind the choices individuals make (perceptions of attractiveness) and how their behaviour impacts greater trends (investment prices). This sparks further questions in terms of existing mathematical principles – how can chaos theory justify the presence of the golden ratio throughout the world? How can the golden ratio be taken advantage of in decision-making beyond technical analysis? Is the golden ratio a foolproof measure of aesthetic pleasure and assumptions of how things work in life? Regardless, the identification of the golden ratio in its myriad applications is in itself, a fascinating sensation.

SPECTRUM 16 SPECTRUM VOL.3 MATHEMATICS
SIDEBAR:
References
Gale, D., & Shapley, L. S. (1962). College admissions and the stability of marriage. The American Mathematical Monthly, 69(1), 9-15.
Fett, B. (2006). An in-depth investigation of the divine ratio. The Mathematics Enthusiast, 3(2), 157–175. https://doi. org/10.54870/1551-3440.1047
Henein, M. Y., Zhao, Y., Nicoll, R., Sun, L., Khir, A. W., Franklin, K., & Lindqvist, P. (2011). The human heart: Application of the golden ratio and angle. International Journal of Cardiology, 150(3), 239–242. https://doi.org/10.1016/j.ijcard.2011.05.094

Huntley, H. E. (1970). The divine proportion: A study in mathematical beauty. Dover Publications.
Inanli, S. (n.d.). The Golden Ratio and Rhinoplasty. Prof.Dr.Selçuk İnanlı. Retrieved January 29, 2023, from https://selcukinanli.com/ en/article/the-golden-ratio-and-rhinoplasty#:~:text=The%20 golden%20ratio%2C%20which%20is%20a%20guide%20in%20 plastic%20surgery,more%20beautiful%20it%20is%20perceived Kuepper, J. (2022, July 7). Fibonacci and the Golden Ratio: Technical Analysis to unlock markets. Investopedia. Retrieved January 29, 2023, from https://www.investopedia.com/articles/ technical/04/033104.asp#toc-examples-of-the-golden-ratio
Tamargo, R. J., & Pindrik, J. A. (2019). Mammalian skull dimensions and the golden ratio (‐). Journal of Craniofacial Surgery, 30(6), 1750–1755. https://doi.org/10.1097/scs.0000000000005610
Visconti, G., Visconti, E., Bonomo, L., & Salgarello, M. (2014). Concepts in navel aesthetic: A comprehensive surface anatomy analysis. Aesthetic Plastic Surgery, 39(1), 43–50. https://doi.org/10.1007/s00266-014-0434-z
17
Game Theory

 by Akshay Agarwal
Photo by Luis Villasmil on Unsplash
by Akshay Agarwal
Photo by Luis Villasmil on Unsplash
MATHEMATICS
Jonathan Peterson on Unsplash
Should I write my English essay or finish my chemistry homework?
Should I read “Harry Potter” or “The Murder on the Orient Express”? Should I first brush my teeth or take a shower? Every day, we have to make thousands of decisions—where some are as simple as choosing what side of the bed you wake up on. Although we generally make these decisions subconsciously, how do we actually decide which book to read? Well, our brain subconsciously evaluates the possible outcomes of each
make more sense for me to read “Murder on the Orient Express”, as the potential outcome of reading the same book twice isn’t enticing. The study of accurately evaluating the potential outcomes of different decisions in various scenarios or ‘games’, is known as Game Theory. At the end of this article, you should be able to take any scenario, whether that may be a poker hand or the imperative decision of which side of the bed you wake up on, and break down the decisions to find the objectively best one.

concepts will be with the archetypal Game Theory scenario, The Prisoner’s Dilemma. The scenario is as follows: two friends have been arrested for the same crime, and in separate, they’re given some information—if they confess, but their friend doesn’t, the one who confesses will be freed while the one who stayed quiet will be sentenced to five years in prison. Rather, if both friends stay quiet, they will each be sentenced to only one year in prison. Finally, if both friends confess, they will each be sentenced to three years in prison.
Now…thinking about this situation with words is awfully complicated; therefore,
we can construct a decision-outcome table , pictorially showing the various potential outcomes for each criminal's decision. That table would look like this:
As yowu can see, the rows and columns correspond to each prisoner's decisions, while the two values within each cell correspond to the possible outcomes. Therefore, in the bottom-left cell, the value is (0,5), as when prisoner 2
 Game Theory
Game Theory
19
confesses and prisoner 1 doesn’t, prisoner 2 is freed while prisoner 1 is held captive for another five years.
But now what…what can we deduce from this table? Well, let’s say you’re prisoner 1. If you’re considering the possibility of staying quiet, you look down the column of staying quiet and take your outcomes as the second number in the ordered pair. Therefore, if you stay quiet, your possible outcomes are one year or five-year imprisonment. As you don’t know what your friend’s going to do, the likelihood of those outcomes can currently be thought of as equal, meaning your expected outcome when you stay quiet is 12*(5+1) = 3 years of imprisonment.
Similarly, the table shows that the potential outcomes if you confess are freedom (no imprisonment) and three years
imprisonment. The same computation shows the expected outcome when you confess is 12*(0+3) = 1.5 years imprisonment.
So it’s simple—the expected outcome when you confess is half the years of imprisonment for when you stay quiet… so CONFESS! But unfortunately…Game Theory isn’t so straightforward. If both you and your friend reach the same conclusion, you’re both going to confess. And looking at the table above, both of you confessing is…the worst outcome, as both of you have to endure three years of imprisonment.
So something isn’t making sense. We analyzed the scenario and found the best decision, but if our friend follows the same logic, it actually becomes the worst decision. Why is that the case? Well, it’s a phenomenon in game theory known as the Nash equilibrium, named after mathematician John Nash. It says that sometimes, changing our actions won’t actually change the outcome, as it depends on someone else. In a more common scenario, poker, sometimes bluffing is beneficial if your opponent falls for it (although it’s objectively not correct).

MATHEMATICS
Any game, any problem, and any situation in the world can be modeled and analyzed using the concepts of Game Theory. Here, we’ve explored
20 VOL.2 SPECTRUM 20 VOL.3
the world of action vs outcome analysis, looking at Game Theory concepts such as the Nash equilibrium and decisionoutcome tables.
Hopefully, this should give you the motivation to learn about other, significant ideas in Game Theory, helping you have full awareness and control over the decisions in your everyday life.
References
Friedman, J. W. (1990). Game Theory with Applications to Economics. Oxford University Press, USA.
Hajek, B. (2017). An Introduction to Game Theory. http://hajek. ece.illinois.edu/Papers/GameTheoryDec2017.pdf

Game Theory
21
Photo by Hassan Pasha on Unsplash
by Lauren Lim
Glia: The Lesser Known Brain Cells

What are brain cells? You’ve probably heard of neurons, also called nerve cells. But neurons are only one type of cell composing the nervous system. The second main type
of cell is the glial cell. Some estimates claim that there is a 10:1 ratio of glial cells, or glia, to neurons, but some more recent research estimates that glia are roughly equal in number to neurons (Jabr, 2012).
SCIENCE
In recent years, researchers have discovered many complex functions of glial cells that demonstrate that glial cells have a greater significance in the nervous system than previously thought.
22 SPECTRUM VOL.3
When they were first discovered in the 19th century, glia were thought to only provide structure for neurons and act as the “glue” of the nervous system.
By now, glia have long been known to also support neurons by supplying nutrients, removing waste products, insulating neuron signal transmissions, and performing other duties. Within the broader category of glia are specialized glial cells, such as microglia, astrocytes, oligodendrocytes, satellite cells and Schwann cells (Guy-Evans, 2021).
Neurons have been the focus of neuroscientific research due to their ability to transfer and process information, making them
the basis of neural functioning. Neurons communicate with each other at sites called synapses, and increasing evidence is proving that astrocytes play a major role in synaptic transmission (Araque & Navarrete, 2010).
For one, they maintain the homeostasis of environments around synapses, improving synaptic efficiency. Transmission of neurotransmitters like glutamate is one way that neurons communicate with each other at synapses. However, excess concentrations of glutamate can cause hyperactivity in neuronal networks and even epileptic activity.
To help prevent such pathological issues, astrocytes clear glutamate from synapses. Not only do astrocytes support neuronal communication, but studies have also found that complex information processing in neuron-toastrocyte communication has similarities to neuron-to-neuron communication, proving that glia play an active role in neuronal networks. Variations in calcium ion concentrations inside astrocytes determine cellular excitability, allowing them to make use of electrical signals. Furthermore, astrocytes have specific responses to different neurotransmitters, and even release other own neurotransmitter-like chemicals called gliotransmitters.
Although it might sound reasonable to think that more synapses is better; in fact, the opposite is true. When children develop, their brains form synapses— many more than are needed and many

Glia: The Lesser Known Brain Cells
Photo by Robina Weermeijer on Unsplash
23
more than are efficient. As a result, a process called synaptic pruning is essential for healthy brain development and function. Microglia can engulf synapses, thereby contributing to synaptic pruning (Ji et al., 2013). Aside from participating in brain development, microglia also maintain brain health (Guy-Evans, 2021). When signaled, microglia move to areas of injury or disease to clear dead cells, pathogens, and harmful waste.
Other recent studies have shown that glial cells may be involved in chronic pain. When pain signals travel from the body, or the peripheral nervous system, to the brain, or the central nervous system, glia regulate the intensity and duration of the pain (Dobbs, 2021). When this process goes awry, glia may cause neuroinflammation and prompt nerve cells into sending never-ending pain signals. Microglial, astrocyte, and satellite cell activity have all been found to contribute to chronic pain, but researchers are not yet sure where and why glial functioning goes wrong. The involvement of glial cells would explain why current painkillers aren’t effective: they only target neurons. Previously, researchers had struggled to find the biological basis of chronic pain, but now that they’ve identified glial cells as the issue, there’s more direction for finding a solution. Despite this progress, treatment for chronic pain may still be a while away. Glia perform a range of functions and are so vital for other processes in the nervous system that trying to simply incapacitate them would cause more harm than good.
As new discoveries are made, there has been increasing interest in the function of glial cells. Glia are not only vital in the development and maintenance of the brain, but have also been proven active in neuronal communication. Links between glia and certain neurodegenerative diseases plus the chronic pain issue open up new paths for potential treatments. This research, though, may progress slowly. As National Institutes of Health researcher Dr Doug Fields put it, “neuroscientists have studied neurons for over a century, but they are playing catchup with glia” (Dobbs, 2021).

SCIENCE 24 SPECTRUM VOL.3
Photo by Anna Shvets on Pexels
References
Araque, A., & Navarrete, M. (2010). Glial cells in neuronal network function. Philosophical Transactions of the Royal Society B: Biological Sciences, 365(1551), 2375–2381. https:// doi.org/10.1098/rstb.2009.0313
Dobbs, D. (2021, November 22). How Glial Cells Are Quietly Revolutionizing Chronic Pain Study and Care. The New York Times. https://www.nytimes.com/2021/11/09/well/mind/glialcells-chronic-pain-treatment.html

Guy-Evans, O. (2021, June 9). Glial Cells Types and Functions - Simply Psychology. https://www.simplypsychology.org/ glial-cells.html
Jabr, F. (2012, June 13). Know Your Neurons: What Is the Ratio of Glia to Neurons in the Brain? Scientific American Blog Network. https://blogs.scientificamerican.com/brainwaves/ know-your-neurons-what-is-the-ratio-of-glia-to-neuronsin-the-brain/
Ji, R. R., Berta, T., & Nedergaard, M. (2013). Glia and pain: Is chronic pain a gliopathy? Pain, 154(Supplement 1), S10–S28. https://doi.org/10.1016/j.pain.2013.06.022
25
Glia: The Lesser Known Brain Cells
by Shreya Srivastava
Dumb Ways to Die: Earth Edition
We’ve all experienced that moment in science class where we first learned that the Sun is going to explode in 10 billion years, and proceeded to have a meltdown about it. Although that issue has now waned to the back of our minds, there are still countless other ways the world can end much sooner than predicted.
Astoningishly, however, a lot of research has not been conducted on the list of possibilities that could end our time on Earth. In fact, Anders Samberg, a catastrophe researcher at the University of Oxford, claimed more research articles are available on dung beetle reproduction than
human extinction (Julia Rosen, 2016). Regardless, the research we do have points us in the direction of endless uncontrollable hazards that could annihilate humanity.

What if there is a Solar Storm?
Although we have a lot to thank the Sun for– it provides adamant radiant heat that nourishes life on planet Earth. However, as much as the radiation helps us, it could also hurt us. A solar storm is when the Sun emits giant bursts of energy in the form of solar flares and coronal mass ejections–a large cloud of energetic and highly magnetized plasma
SCIENCE
Photo by Robina Weermeijer on Unsplash
26 SPECTRUM VOL.3
(Hauptman, 2021). Visually noticeable as the dark splotches on the surface of the Sun (also known as sunspots), a solar flare is when the magnetic lines on the Sun turn taut and twisted, thus causing gigantic electromagnetic energy storms.
Although Earth’s magnetic field and insulating atmosphere protects us from vigorous solar flares, we are still constantly under the risk of the sheer electromagnetic power from a flare causing a worldwide blackout (Brandon Specktor, 2022).
Out of hand, a solar flare can single-handedly be responsible for the breakdown of power grids, internet connections and mobile phones.
A day without my phone and WiFi? That really does seem like the end of the world. Luckily for us, we can sleep soundly at night knowing that scientists all over the
Ways
Die: Earth
world are constantly monitoring the Sun’s activity and should be able to detect any detrimental solar storms, should there be one, a day in advance (Dunning, 2022).
What if the Sun exploded tomorrow?
To be completely safe from a supernova, a solar explosion, we would need to be at least 50 to 100 million light years away. However, if the Sun were to explode, only the portion of Earth facing it would immediately boil out of existence. The remaining portion of Earth would go pitch black and experience a rise in temperature of 15 times hotter than the Sun’s surface (Zelvis, 2022). Additionally, without the gravitational pull of the Sun keeping us in orbit, we would likely drift off into space.

Essentially, there is absolutely no chance of survival of humanity if the Sun were to unexpectedly explode tomorrow.
Even if we were to gain the security of another star, by the time that would happen, we would be long gone. However, if we knew a day in advance of the Sun’s explosion, we could add a thousand years to the existence of humans because we could potentially prepare for it by moving underground (Peter, 2019). But, after a
Photo by Pixabay on Pexels
Dumb
to
Edition
27
thousand years, the cosmic radiation and meteor impacts would have caused too much damage to sustain life (Peter, 2019). In summary, you should hope the Sun doesn’t explode tomorrow.
tremendous damage in the form of powerful tsunamis and earthquakes. High speed winds would scour the landscape completely clean.
What if the Earth stopped rotating?
Although unlikely because of the amount of energy it would require, if the Earth were to stop rotating, humanity would most probably not survive because of the amount of natural disasters it would cause.

The Earth’s core travels at approximately 1000 miles an hour, so if it were to suddenly halt, everything would fly eastward (Diamond, 2018).
Not just the things stored in your room, but rocks and mountains and oceans. All of this movement would likely cause
Furthermore, if the halt in rotation were to be more gradual and subtle, the effects would still be detrimental. Our day would last much longer than 24 hours (perhaps one day would last a year), so our biological circadian rhythms would be severely disrupted. Therefore, our normal biological processes and routines could be completely upended (Scharping, 2021). Not only do organisms rely on Earth’s rotation, but the atmosphere does as well. Changes in temperatures and wind currents would affect the natural climate of lots of landscapes. Perhaps frozen tundras might become habitable and wet landscapes would turn arid, thus disrupting the habitat of countless animal species, including humans (Scharping, 2021). On the positive side, we could look forward to some very, very long sunsets (but at what cost?).
Conclusion
None of these situations seems ideal for humans to experience, but the chances of any of them happening are almost slim to none, so don’t let this article steal your sleep at night. Instead, focus on appreciating Earth’s natural, everchanging beauty a bit more. Maybe colors will begin to look brighter and the air will feel fresher. Relish in the pure beauty of our solar system and the magnificent, overbearing power it holds over the fate of humanity.
Photo by NASA on Unsplash
28 SPECTRUM VOL.3 SCIENCE
References
Brandon Specktor. (2022, August 25). Could a solar storm ever destroy Earth? Livescience.com. https://www. livescience.com/solar-storm-destroy-earth
Diamond, A. (2018, August). What Would Happen if the Earth Stopped Rotating? and More Questions From our Readers. Smithsonian Magazine. https://www.smithsonianmag.com/ history/what-happen-earth-stopped-rotating-180970312/ Dunning, H. (2022, May 18). Solar storms can be predicted a day in advance, shows mission to the Sun | Imperial News | Imperial College London. Imperial News. https:// www.imperial.ac.uk/news/236539/solar-storms-predictedadvance-shows-mission/
Hauptman, M. (2021, July 20). False warnings about solar storms have gone viral. Here’s what the flares actually do to Earth. Washington Post. https://www.washingtonpost.com/ science/2021/07/19/solar-storms-explainer/
Julia Rosen. (2016, July 14). Here’s how the world could end— and what we can do about it. Www.science.org. https:// www.science.org/content/article/here-s-how-world-couldend-and-what-we-can-do-about-it
Peter. (2019, December 24). What If the Sun Exploded Tomorrow? What If Show. https://whatifshow.com/what-ifthe-sun-exploded-tomorrow/
Scharping, N. (2021, April 15). What would happen if Earth stopped spinning? Astronomy.com. https://astronomy.com/ news/2021/04/what-would-happen-if-the-earth-stoppedspinning
Zelvis, N. (2022, January 5). What Would Happen If The Sun Exploded? Https://Nightskypix.com/. https://nightskypix.com/ what-would-happen-if-the-sun-exploded/
 Glia: The Lesser Known Brain Cells
Glia: The Lesser Known Brain Cells
29
Photo by Anders Drange on Unsplash
by Daniel Ng
The Microbiome Revolution: Unlocking its Full Potential for Improved Health
A microbiome is a collection of microorganisms, or microbes, such as bacteria, viruses, and fungi. The gut microbiome is essentially a complex ecosystem of microscopic living things residing in our digestive tracts. There is a common misconception that bacteria are only associated with disease, but it would be impetuous to distinctly classify them as “good” or “bad” as they are also essential for maintaining a healthy heart, weight, immune system, and many other organs and processes. The role of these microbes, the linkage between the gut
microbiome and particular health conditions, and the emerging research for potential treatments and implementations will be explored below.

"Gut health is immensely important for all aspects of our well-being at the level of our brain and at the level of our body, and there are simple, actionable things that we can all do in order to optimize our gut health."
SCIENCE
Photo by CDC on Unsplash
30 SPECTRUM VOL.3
This is why learning about the gut microbiome and its mechanisms as well as the protocols in which one can take to optimize gut health may prove extremely beneficial.
Fun fact: Humans have more bacterial cells than human cells.
Immune System
The gut microbiome and immune system are closely tied. The gut microbiome plays a vital role in regulating our immune system, such that it oversees the body’s reaction to infections or pathogenic viruses and communicates with immune cells on how to fight them off, training them so that they could maintain immune homeostasis. Microbial diversity within the gut microbiome is a crucial part of aiding the immune system and detecting and distinguishing harmful pathogens and harmless bacteria, as well as soothing or triggering inflammatory responses. An imbalance of microbial species, or dysbiosis, can lead to many harmful effects. For instance, despite an absence of antigens or injury to the body, healthy organs and tissues can be attacked due to false triggering of bodily response. This is known as chronic inflammation, which can potentially lead to diabetes, cancer, disease, stroke, or other health issues. This shows the importance of maintaining a healthy and rich gut microbiome. Although genetics plays a vital role in determining the
dynamic of a microbiome, exogenous factors such as drinking, smoking, poo nutrition, and many other externalities can endanger the immune system. Luckily, its susceptibility can also be used to our advantage as we can alter the composition of a microbiome through diet and lifestyle decisions.
Protocol
“Your microbiome is what you eat.” (Carver-Carter, 2022) An ecosystem with a wide variety of species has a higher probability of survival after a calamity than one with a narrow range. Likewise, too much diversity is also harmful. Certain habits and supplementation to avoid include a diet lacking fiber, a sedentary lifestyle, immoderate antibiotics, and stress. Microbiota dysbiosis can be procured via the typical Western diet consisting of highly processed foods with elevated levels of sugar, saturated and trans fats. The dangers of such an eating regime have been linked to cognitive impairment, emotional disorders, diabetes, coronary disease, etc. In contrast, numerous studies indicate that a Mediterranean diet that emphasizes healthy fats, water as a primary beverage, and daily physical exercise is associated with increased lifespan, healthy aging, weight loss, and prevention of cardiovascular diseases, etc. Learn more about approaches from immunologist Dr. Jenna Macciochi.
The Microbiome Revolution: Unlocking its Full Potential for Improved Health
31
Mental/Emotional Health
A healthy gut is imperative for normal central nervous system (CNS) functioning. This is because the gut has a bidirectional relationship with the CNS as well as other major body systems, meaning they are capable of influencing each other. Just as a troubled intestine can distress the brain, the brain can signal the gut. Essential bodily functions such as the commerce of neurotransmitters, hormones, and immunological factors are all known to communicate with the brain through the autonomic nervous system or directly. Recent research on the existence of the gut-brain axis has shown that conditions in the gut microbiome may affect CNS disorders such as depression, schizophrenia, anxiety, etc. This indicates that the prescription of probiotics and clinical therapy may potentially serve as a treatment for certain mental disorders. An example where the deregulation of neurochemical
Pro-inflammatory cytokines are partly responsible for stimulating the HPA, and where chronic or elevated stress levels may cause the release of corticotropin through the hypothalamus. This then stimulates the release of adrenocorticotrophic hormone (ACTH) which in turn increases cortisol (stress hormone) levels. Dysregulation of the HPA axis is one of the many signal transduction pathways that can overall contribute to depression and anxiety.
Protocol
It is evident from accumulating research that the gut microbiome can have a major effect on mental/ emotional health. Antecedent treatment of individuals exhibiting depressive symptoms is often prescribed with therapy or antidepressants. The latter has undergone a comparison of the efficacy of probiotics in regulating cortisol levels, HPA axis, and anxiety symptoms. It was discovered that not only do they share similar positive effects, but probiotics might also be superior in their ability to alleviate ailing mental health conditions with fewer side effects. They are also lower in cost and higher in availability. However, probiotics aren’t regulated by the FDA and require more research before consideration for implementation in psychiatry. Though more precaution is necessary for synthetic supplements, there are many natural probiotics that are much safer and available such as yogurt, kefir, kimchi, kombucha, etc.

32 SPECTRUM VOL.3 SCIENCE
These fermented foods are packed with yeast and bacteria and along with a rainbow of vegetables can be experimented with through gradual implementation to increase the biodiversity of microbes in your gut. Besides diet, sufficient sleep and exercise can also help. The Centers for Disease Control and Prevention suggests 150 minutes of exercise per week, meanwhile, the National Sleep Foundation recommends 7-9 hours of sleep per night for adults.
Conclusion
There are endless pathways in our body that through combined effort and synergy regulate and sustain bodily functions. The discovery of these pathways is crucial in increasing our understanding and awareness of how the human body works, as well as formulating ways to optimize and adjust conditions that best suit our individual needs and wants. The purpose of this article is to equip you with a basic understanding of the importance and potential of the gut microbiome.
References
Robertson, R. (2017, June 27). Why the Gut Microbiome Is Crucial for Your Health. Healthline; Healthline Media. https:// www.healthline.com/nutrition/gut-microbiome-and-health
Huberman, A. (2022, February 28). How to Enhance Your Gut Microbiome for Brain & Overall Health. Huberman Lab. https://hubermanlab.com/how-to-enhance-your-gutmicrobiome-for-brain-and-overall-health/
Christovich, A., & Luo, X. M. (2022). Gut Microbiota, Leaky Gut, and Autoimmune Diseases. Frontiers in Immunology, 13. https://doi.org/10.3389/fimmu.2022.946248
Carver-Carter, R. (2022, March 25). The Link Between Your Gut Microbiome And Immune Health. Atlas Biomed Blog | Take Control of Your Health with No-Nonsense News on Lifestyle, Gut Microbes and Genetics; Atlas Biomed blog | Take control of your health with no-nonsense news on lifestyle, gut microbes, and genetics. https://atlasbiomed.com/blog/themicrobiota-immune-axis/#immune-system
Diet Review: Mediterranean Diet. (2018, January 16). The Nutrition Source. https://www.hsph.harvard. edu/nutritionsource/healthy-weight/diet-reviews/ mediterranean-diet/
Clapp, M., Aurora, N., Herrera, L., Bhatia, M., Wilen, E., & Wakefield, S. (2017). Gut Microbiota’s Effect on Mental Health: The Gut-Brain Axis. Clinics and Practice, 7(4), 987. https://doi. org/10.4081/cp.2017.987

The
Health
Microbiome Revolution: Unlocking its Full Potential for Improved
33
Photo by CDC on Unsplash
90 Seconds Till Midnight: Doomsday Clock
by Triston Wong
Midnight—a
full apocalypse; the utter annihilation of humanity.
Thiswas the purpose of the Doomsday Clock created by the Bulletin of Atomic Scientists in 1947. The clock is a metaphor used to create urgency and alert the public about the current position of society and the reasons for its failure: climate change, disruptive technologies, and atomic weapons.
The closer the clock gets to midnight, the closer humanity is to its untimely demise
(Bulletin of Atomic Scientists, 2023). The furthest the clock has ever been was 17 minutes, after the Cold War. Today, it is the nearest it has ever been.
The simplistic design of the Doomsday Clock has come a long way since its creation. When nuclear physicist Alexander Langsdorf Jr. was called to the Manhattan Project in 1943—a research project to develop the atomic bombs—he, like many of his colleagues, was met with unease. The end of World War II only emphasized the dread, which left many to ask: how would the human race end itself? To answer the question, Langsdorf and his colleagues developed a newsletter called the Bulletin of Atomic Scientists to alert the public of their greatest dangers. And as many would be surprised,

SCIENCE
Photo by Jon Tyson on Unsplash
34 VOL.2
34 VOL.3
SPECTRUM
scientists' biggest struggle was designing a cover.
Luckily, Langsdorf’s wife, Martyl, was a landscape artist who volunteered to create one. At first, she considered using uranium as a symbol after its involvement in the nuclear arms race (Bulletin of Atomic Scientists, 2023). But understanding the urgency and goal of the magazine, the artist wanted to create something that could educate the general public. It was then that Martyl sketched out the clock, and in 2007, the atomic clock became the official logo of what is now a magazine (Bierut, 2015).
Arbitrarily set to seven minutes at its creation (Benedict, 2023), the
Bulletin’s Science and Security Board consisting of scientific experts and Nobel laureates now manages and analyzes the world’s current state before setting a time. The board, as of 2007, started to take into account other global dangers, including climate change and cybersecurity threats (Bulletin of Atomic Scientists, 2023).
On January 24th, 2023, the latest statement regarding the clock at this current time was released, and the Bulletin of Atomic Scientists announced that the clock has moved 10 seconds closer to midnight; previously only 100 seconds. The last time the clock moved was in 2020 due to many events, mainly COVID-19. Under their yearly statement that describes the reasoning behind the

90
Seconds Till Midnight: Doomsday Clock
Photo by Dan Meyers on Unsplash
35
Doomsday Clock’s state, the Bulletin mentions that a large influence that changed the clock was the war between Russia and Ukraine.
The war has a major impact on the threat of nuclear weapons. As stated, “Russia’s thinly veiled threats to use nuclear weapons remind the world that escalation of the conflict is a terrible risk” (Mecklin, 2023). This, combined with Russia’s attack on nuclear reactor sites in Chernobyl and Zaporizhzhya alongside the only nuclear weapons treaty for Russia and the United States in jeopardy, makes many unsure of the coming events in the future.

There are additional threats
regarding the testing of missiles and development of nuclear weapons from many countries including North Korea, China, and Iran, as well as a lack of treaties that prevent future damage. Alongside this, the undermined effects of climate change have continued to be severely damaged in the light of the war in Ukraine. With Russia’s refusal to give resources in response to many countries’ sanctions, oil has become more of a competitive resource than it already is. This has led to a surge of a counterpart of oil and natural gas, which are also detrimental to the environment. While many other threats and dangers are mentioned, it is highly
SCIENCE
Photo by Jon Tyson on Unsplash
36 VOL.2 SPECTRUM 36 VOL.3
PetersonPhoto by Jon Tyson on Unsplash
encouraged to read the magazine for yourself on the Bulletin’s official website for a more detailed explanation of these concurrent events.
Today, the Doomsday Clock is a global symbol and message that has pulled the eyes of many to the attention of the many dangers regarding the human race. As stated by Robert K. Elder and J.C. Gabel who wrote, The Doomsday Clock at (age) 75, it is “the most powerful piece of informational design of the 20th century” (2022).
While many aren't fans of the clock for its futuristic-like implications for our future, the creators of the clock only wish for it to hum in the background of humanity’s life: a reminder of the volatile power that stands today. It is also why the clock is only updated in January (Newcott, 2022).
During this time, articles are written every year about the Doomsday Clock, the most prominent being from The Guardian (2022), National Geographic (2022), and The Times (2023), all of which share the clock’s unique qualities. In light of the events over many years, the Doomsday Clock has become a method to analyze and compare how society has changed since the Second World War (Benedict, 2023). While it is a symbol of demise and ultimately, the end of the human race, it is also a reminder of something important: hope. The fact that the clock has not struck midnight simply means there are possibilities to change the events of the future. Hopefully, for the better. A message is all it takes to make meaningful change.
References

Benedict, K. FAQ. Bulletin of the Atomic Scientists. https:// thebulletin.org/doomsday-clock/faq/
Bierut, M. (2015, November 5). Designing the Doomsday Clock. The Atlantic. https://www.theatlantic.com/ entertainment/archive/2015/11/doomsday-clock-michaelbierut-design/412936/
Borger, J. (2022, January 19). Is midnight upon us? doomsday clock panel to set risk of global catastrophe. The Guardian. https://www.theguardian.com/world/2022/jan/19/ismidnight-upon-us-doomsday-clock-panel-to-set-risk-ofglobal-catastrophe
Bulletin of the Atomic Scientists. (2023, January 26). A time of unprecedented danger: It is 90 seconds to midnight. Bulletin of the Atomic Scientists. https://thebulletin.org/doomsdayclock/
Mecklin, J. (2023, January 24). Current time - 2023. Bulletin of the Atomic Scientists. https://thebulletin.org/doomsdayclock/current-time/
Newcott, B. (2022, January 21). The atomic scientists' doomsday clock is now 75-and threats to civilization still abound. National Geographic. https://www. nationalgeographic.com/history/article/the-doomsdayclock-is-now-75-and-its-still-ticking
90 Seconds Till Midnight: Doomsday Clock
37
DNA Data Storage
 by
by
SCIENCE
Photo by Sangharsh Lohakare on Unsplash
Irene Choi
From writing on papers to saving on computers, our way of storing data massively changed over the past. Hardwares, floppy drives, and SSDs do have benefits compared to data storage on paper; for example, they are more durable of outside changes in condition and they take up less space and time compared to writing one by one. However, would it be our best method of data storage in the long term? What might be other alternatives?
How does the current system work?

First of all, let’s look at the problems of the current system. We typically use data storage centers to store any crucial data that needs to be protected for a long period of time. Data storage centers serve three main purposes: compute, storage and networking. Essentially, they process the data to run the application, physically store the data with backups, and connect the data with different centers when necessary. Storing the data in the long term is especially important for corporations or organizations which requires frequent recall of information stored. The equipment in large scale data storage centers allow organizations to continue storing information. (Networkworld, 2020)
What are the downsides of the current system?
1. Not Robust
Storage centers not only require technical equipment to protect the information, but also require extensive facilities to keep the hardware
and software running: including power subsystems, ventilation and cooling systems, backup generators, uninterruptible power supplies (UPS), and cables to connect external network operations. These facilities are open to the impact of external changes in condition, and can be consumed - meaning they have to be changed or cleaned constantly while using. This makes it less costeffective to use in the long term.
2. Low information density
Storage centers also require a large amount of space to store the information. Compared to the space they take up, however, the information they can hold isn’t much. This makes the use of space ineffective and unnecessary; this also contributes to a higher cost.
DNA Data Storage
3. Each media requires a special reader
Just like how a key and a lock works in daily lives, each media composed of data requires a specific reader to analyze or recall the data. The space and cost to buy or build every reader can be negligible if the media is small enough; however, because we need a great amount of information to be stored, the money and space we need can’t simply be ignored. This contributes to a greater inefficiency of using money, especially by profit seeking corporations.
of all, data storage in DNA can store up to 1018 bytes per mm^3, which is about 6 times denser than the densest storage method available today. This increase in density allows the preservation of data for a long time at low energy costs. DNA storage method also makes it easier to replicate the data using the PCR technique.
(Data storage center in Oregon)

As shown in the picture, about 5700m^2 big data storage centers can contain 1 exabyte of information (100,000,000 gigabyte). Considering that a middle size soccer field can be 5000m^2, the data storage center can be interpreted as taking up a great amount of space.

(Matange, 2021)
DNA Data Storage?
Understanding the limitations of current data storage techniques, why is DNA data storage an effective alternative? First
There are three main types of DNA data protection: archival storage method, working storage method, and shortterm dynamic storage. Archival storage method, one of the long-term storage methods - encapsulates the DNA to protect the data that is not often accessed. The working storage method is a short term storage method which freezes or dries the data, and the short-term dynamic storage method, used for the most frequently accessed data, secures the data in a liquid form. Essentially, all three data storage methods secures the data by transforming the original binary data to a DNA code (G/C = 0, A/T = 1). This not only increases the efficiency of data protection, but also allows better data replication as DNA has a characteristic of self-replication. (Ceze, 2019)
SCIENCE
The cost and time, which is the problem currently faced, is expected to improve in the future.
40 VOL.2 SPECTRUM 40 VOL.3
(DNA storage method diagram)
Limitations?
Although DNA storage methods are expected to develop, there are limitations to current DNA storage methods that limits our ability to fully utilize the system. For example, the methods are not fully stable, as the DNA is still exposed to external conditions and can be damaged by small condition changes in humidity, temperature, and many other factors. Moreover, DNAs cannot fully secure the data if the data exceeds the 10*10 binary form. Thus, it is yet unable to contain and replicate the data we need. These limitations are to be addressed, and with future research, DNA data storage methods can be a better means for data storage.


References
Networkworld. What are data centers? How they work and how they are changing in size and scope. 2020. [online]
https://www.networkworld.com/article/3599213/whatare-data-centers-how-they-work-and-how-they-arechanging-in-size-and-scope.html [Latest accessed: 15th May]
Matange. DNA stability: a central design consideration for DNA data storage systems. 2021. [online]
https://www.nature.com/articles/s41467-021-21587-5 [Latest accessed: 15th May]
Ceze. Molecular digital data storage using DNA. 2019. [online]
https://www.nature.com/articles/s41576-019-0125-3 [Latest accessed: 15th May]
DNA Data Storage
41
Coronary Artery Disease and its Treatment
 by Morgan Ahn
by Morgan Ahn
SCIENCE
Photo by Robina Weermeijer on Unsplash
Introduction
“Coronary Heart Diseas`e is a type of heart disease where the arteries of the heart cannot deliver enough oxygenrich blood to the heart.” (National Heart, Lung, and Blood Institute)
Coronary Heart Disease (CHD) has been a detrimental factor in death in the 21st century. According to the Centers for Disease Control and Prevention (CDC), Heart disease is an overall leading cause of death in the United States regardless of ethnic group. It has been mentioned that “One person dies every 34 seconds from

cardiovascular disease.” Specifically, in 2020, approximately 697,000 people in the United States died. Among them, about half suffered from Coronary Artery Disease. Moreover, about 20.1 million people have CHD or CAD. The percentage of the death rate of the race or ethnic groups varies; however, they have a low percent percentile difference and an average of 18.2%.
Compared to other body diseases, CHD/ CAD is severe since it can weaken the heart muscle over time, which may lead to a heart murmur and heart failure. This happens because the heart cannot
pump the blood properly for the entire body system as it should. Also, by having a CAD, the patient may show chest pain and feel a block of blood flow to the heart and other muscles. A heart attack may also occur, which has symptoms of chest
pain, nausea, or shortness of breath.
Overview of the Heart System
The heart is the most significant organ in the body. It serves as a pump to circulate
Coronary Artery Disease and its Treatment
“Coronary Heart Diseas`e is a type of heart disease where the arteries of the heart cannot deliver enough oxygenrich blood to the heart.” (National Heart, Lung, and Blood Institute)

Coronary Heart Disease (CHD) has been a detrimental factor in death in the 21st century. According to the Centers for Disease Control and Prevention (CDC), Heart disease is an overall leading cause of death in the United States regardless of ethnic group. It has been mentioned that “One person dies every 34 seconds from cardiovascular disease.” Specifically, in 2020, approximately 697,000 people in the United States died. Among them, about half suffered from Coronary Artery Disease. Moreover, about 20.1 million people have CHD or CAD. The percentage of the death rate of the race or ethnic groups varies; however, they have a low percent percentile difference and an average of 18.2%.
Compared to other body diseases, CHD/ CAD is severe since it can weaken the heart muscle over time, which may lead to a heart murmur and heart failure. This happens because the heart cannot pump the blood properly for the entire body system as it should. Also, by having a CAD, the patient may show chest pain and feel a block of blood flow to the heart and other muscles. A heart attack may also occur, which has symptoms of chest

SCIENCE
44 VOL.2 SPECTRUM 44 VOL.3
pain, nausea, or shortness of breath.

Overview of the Heart System

The heart is the most significant organ in the body. It serves as a pump to circulate the blood to the entire body system. It has four rooms of blood (based on humans): atria and ventricles on both the left and right. Humans have a closed circulatory system in which blood moves from the heart to the lung and circulates the same route continuously. It is beneficial for fast and long-distance transport and controlling blood flow. Going back to the heart composite, a ventricle is the heart chamber that pumps blood out of the heart. On the other hand, the atrium is the heart chamber where blood reenters the heart. Lastly, we call the blood vessel that carries the blood out of the heart an artery, and the blood vessel carries blood into the heart as a vein. All the other small blood vessels that we cannot distinguish easily are called capillaries. An artery has thick elastic walls and a small circumference since the blood pressure it needs to endure is very high. However, a vein has thin, less elastic walls with valves and a large
circumference. To prevent the case of blood from flowing backward, valves are very important in a vein. The capillary is extremely thin and transfers materials between blood and the body. Our heart passes through the diastole and systole, relaxation, and contraction. Initially, cardiac diastole happens, atrial systole and ventricular diastole, and atrial diastole and ventricular systole occur. To conclude, humans should have rhythmic heart beating: SA node and AV node. If the person has a problem with it, we call it arrhythmia, a heart rate disorder. SA node is a sinoatrial node when a group of specialized cardiac muscle cells in the right atrium – pacemaker - makes a sound. AV node is an atrioventricular node - it is also called delay electrical
Coronary Artery Disease and its Treatment
45
Photo by Robina Weermeijer on Unsplash
impulse from the atria to the ventricle to allow atria to empty blood. (based on this information, QRS complex can be established)
Introduction to Three types of CAD
There are three types of CAD: obstructive, nonobstructive, and spontaneous.
Obstructive Coronary Artery Disease occurs when the arteries gradually get narrower due to plaque or other material compilation. This is the most common disease that happens to the majority of CAD patients. It can eventually block the artery and stop the blood from going through the heart, and if a sudden blockage happens, it is called a heart attack.
Nonobstructive Coronary Artery Disease, however, is not related to plaque compilation. There are a few causes, such as constrictions at inappropriate times (coronary vasospasm), damage of artery lining (endothelial dysfunction), malfunction in smaller artery branches (microvascular dysfunction), and compression of coronary arteries from heart muscle (myocardial bridging). Although the cause of CAD is quite different, it can still cause similar symptoms, including shortness of breath. This type can develop regardless of age and race, but females are more likely to gain compared to males.
Spontaneous Coronary Artery Disease Dissection (SCAD) is when the wall of the artery partially or fully blocks the
blood flow. This happens unexpectedly and often results in a heart attack. The symptom of it is unique from others: neck/back pain and sensation of pressure.
Treatment of CAD
The treatment of CAD depends on the type of CAD that person has. Some might need surgery, but others can be okay by just changing their lifestyle.
For Obstructive CAD, it is trivial to maintain a healthy weight, eat a healthy diet, exercise, reduce alcohol intake, and sleep seven to eight hours each night. Additional medical pills that lower blood pressure or cholesterol might be helpful. There are also minimal invasive procedures: Percutaneous coronary intervention (PCI) and Atherectomy. PCI sends a thin tube called a catheter with the deflated balloon and inflates it inside the artery, which helps compress the plaque. Also, an atherectomy can be used if the plaque is very hard and cannot compress with the PCI. It is a small drilllike machine that is lasered through the catheter, breaks, and then removed. The
SCIENCE
46 VOL.2 SPECTRUM 46 VOL.3
References
Centers for Disease Control and Prevention. (2021, July 19). Coronary artery disease. Centers for Disease Control and Prevention. Retrieved February 6, 2023, from https://www.cdc.gov/heartdisease/coronary_ ad.htm#:~:text=Narrowed%20arteries%20can%20 cause%20chest,the%20rest%20of%20your%20 body.&text=Over%20time%2C%20CAD%20can%20 weaken,blood%20the%20way%20it%20should.
Centers for Disease Control and Prevention. (2022, October 14). Heart disease facts. Centers for Disease Control and Prevention. Retrieved February 6, 2023, from https://www.cdc.gov/heartdisease/ facts.htm#:~:text=Heart%20disease%20is%20 the%20leading,groups%20in%20the%20United%20 States.&text=One%20person%20dies%20every%20 34,United%20States%20from%20cardiovascular%20 disease.&text=About%20697%2C000%20people%20 in%20the,1%20in%20every%205%20deaths.
Coronary artery disease types. Aurora Health Care. (n.d.). Retrieved February 6, 2023, from https://www.aurorahealthcare.org/services/heart-vascular/ conditions/coronary-artery-disease/types
Encyclopædia Britannica, inc. (n.d.). Heart. Encyclopædia Britannica. Retrieved February 6, 2023, from https://www.britannica.com/science/heart
NHS. (n.d.). NHS. NHS choices. Retrieved February 6, 2023, from https://www.nhs.uk/conditions/coronary-heart-disease/
U.S. Department of Health and Human Services. (n.d.). What is coronary heart disease? National Heart Lung and Blood Institute. Retrieved February 6, 2023, from https://www.nhlbi.nih.gov/health/coronary-heart-disease

Coronary Artery Disease and its Treatment
47
Photo by Robina Weermeijer on Unsplash
The Psychological Effect of Stress on Performance and Learning Memory
 by Anna Hyunjin Choi
Photo by Luis Villasmil on Unsplash
by Anna Hyunjin Choi
Photo by Luis Villasmil on Unsplash
SCIENCE
With the recent new developments and complex networks, people are required to receive, understand and process a plethora of information flowing in their daily livesespecially in highly intellectual and demanding environments such as workplaces and
Indeed, pressure and stress come as a set to maintain oneself in this society. Stress may act as a positive stimulus to motivate individuals to work harder by creating an adequate amount of tension, but otherwise, it may cause harmful consequences, leading to an imbalance in one’s well-being. Likewise, it is crucial to grow the ability to control stress factors. In this regard, numerous academic research has explored key determinants of one’s stress levels, including external factors such as global issues, as well as internal factors like mood shifts and minor psychological stimuli.
Definition of Stress
By definition, “stress” refers to the physiological and psychological reaction triggered by a stressor, either external or internal, creating an unstable, tensioninduced mental state (Ness and Calabrese,
2016). Starting from students who are raised in stressful academic environments with the demands of assignments and grades to fully grown adults in workplaces who are responsible for their own households, it is apparent that stress is now simply a part of daily life. In recent years, the number of reports of unhealthy life patterns and changes in behavior has elevated. For example, in the United Kingdom, up to 49% of adults have spotted changes in behavior due to stress, while 51% and 61% of adults felt either anxious or depressed due to stress respectively (Mental Health Foundation).
Emotional and physical well-being is crucial to sustaining a balanced, healthy life. “Well-being” refers to having a positive and satisfying life, often including workload balance with social life, connecting with other people, and maintaining a regular daily routine. If stress is not regulated and managed properly, well-being definitely would be hard to establish, therefore resulting in psychological effects.
Types of Memory
Memory, also crucial to functioning in a healthy life, is defined to be “the ability to use the past in the service of the present” (Karpicke and Lehman, 2013). Psychologists mainly subdivide memory into two categories- implicit memory and explicit memory.
Implicit memory is a form of memory that is relatively long-lasting and does not require conscious retrievals, such as
of Stress on Performance and Learning Memory
Introduction The Psychological Effect
49
Memory includes steps to be processed in the brain- sensory memory, short-term memory, and long-term memory.
Sensory memory simply refers to the moment sensory receptors take in information from the environment and send it immediately to the brain, which lasts half of a second if it is iconic, visualizing images and symbols, and around three to four seconds if it is echoic, meaning that the memory is stored in the form of sound (Weiten, 2003). During this stage, it can be said
that almost no information is stored in the brain because it is so brief.

Short-term memory, also known as working memory, has limited capacity and can hold a couple of pieces before the information is disposed of (Weiten, 2003). It is easily misconceptualized that short-term memory only is the memory capacity before the information is stored in long-term memory, but short-term memory also acts as a space to retrieve data from long-term memory to bring into the conscious level while conducting a specific task. Afterward, it is sent back to long-term memory.
Unlike short-term memory, longterm memory has limitless storehouse capacity, meaning it can hold as many items as possible (Weiten, 2003). There are several processes required when transitioning into these memories, which is called encoding (Weiten, 2003). Through various encoding strategies that one may acquire, such as using mnemonic devices, priming, and many others, information is encoded into the brain, which is how memory is consolidated. However, in the process of memory smoothly transitioning through and consolidating in long-term memory capacity, stress often interferes by intensifying emotional memory, being called “a strong modulator of memory function”(Luethi, 2008).
Past Studies
The relationship between the two factors has long been studied in the field of general sciences. However, findings drawn from each study seem to still
50 SPECTRUM VOL.3 SCIENCE
differ, making it more difficult to reach a consensus about the explicit impact of stress on working memory and performance.
A study was conducted to test working memory-related task performance in 31 healthy male subjects after exposing them to varying stressors (Gärtner, et al., 2014). Researchers found that acute stress decreases frontal theta activity, which overarches to a variety of behavioral functions crucial in our daily lives such
as attention, alertness, and orientation, usually important in highly demanding tasks (Stylios and Chen, 2016). To support the such conclusion, another study conducted in 2015 yielded results that presented poor working memory and overall performance based on frontal-theta activity in the hippocampus, with anxiety and stress both taken into account (Shi, et al., 2015).
Nevertheless, more studies argued otherwise. In a study assessing the effects of stress and cortisol levels on a

The
Effect of Stress on Performance and Learning Memory
Psychological
51
Photo by Elisa Ventur on Unsplash
comprehensive variety of memory tasks in male human subjects which require the usage of all three types of memory, verbal working memory was found to have imposed performance while areas in perceptual priming and contextual priming showed no differences (Luethi, et al., 2008). Overall, findings indicated that social stressors certainly do play a role in memory impairment, but not always in general performance. \

Another meta-analysis study claimed that the impact of acute stress is “case by case”. In contrast to implicit memory, which can easily be influenced, the effect of prior acute stress in explicit memory is less apparent, frequently displaying neither performance nor short-term memory immediately after training (Sandi, 2013). Furthermore, other studies have shown evidence parallel to the hypothesis that stress and glucocorticoids impair the retrieval of memory which is primarily dependent on the hippocampus (Sandi, 2013).
Conclusion
It is clear that the relationship between stress and working memory and performance certainly does exist. However, there are still disagreements and questions raised regarding how exactly stress affects the two most crucial functions of our bodies. It cannot be denied that finding the distinct causeand-effect relationship between the two factors is certainly complex and difficult with the amount of information unveiled at the moment. Some studies are especially hard to generalize because of
the limitations in the variety of subjects and other confounding variables. Yet, scientists and researchers are still striving to investigate more on the relationship between the two factors through creative approaches even at this moment.
52 SPECTRUM VOL.3 SCIENCE
References
Gärtner, M., Rohde-Liebenau, L., Grimm, S., & Bajbouj, M. (2014). Working memory-related frontal theta activity is decreased under acute stress. Psychoneuroendocrinology, 43, 105–113. https://doi.org/10.1016/j.psyneuen.2014.02.009
Karpicke, J. D., & Lehman, M. (2013). Human memory. Oxford Bibliographies Online Datasets. https://doi.org/10.1093/ obo/9780199828340-0107

Luethi, M. (2008). Stress effects on working memory, explicit memory, and implicit memory for neutral and emotional stimuli in healthy men. Frontiers in Behavioral Neuroscience, 2. https://doi.org/10.3389/neuro.08.005.2008
Ness, D., & Calabrese, P. (2016). Stress effects on multiple memory system interactions. Neural Plasticity, 2016, 1–20. https://doi.org/10.1155/2016/4932128
Sandi, C. (2013). Stress and cognition. WIREs Cognitive Science, 4(3), 245–261. https://doi.org/10.1002/wcs.1222
Schott, B. H., Henson, R. N., Richardson-Klavehn, A., Becker, C., Thoma, V., Heinze, H.-J., & Düzel, E. (2005). Redefining implicit and explicit memory: The functional neuroanatomy of priming, remembering, and control of retrieval. Proceedings of the National Academy of Sciences, 102(4), 1257–1262. https://doi.org/10.1073/pnas.0409070102
Shi, Z., Gao, X., & Zhou, R. (2015). Frontal theta activity during working memory in test anxiety : NeuroReport. LWW.

Stalling, R. B., & Weiten, W. (2003). Weiten’s psychology: Themes and variations (10th ed.). Wadsworth Publishing Company.
Stress: Statistics. (n.d.). Mental Health Foundation. Retrieved February 5, 2023, from https://www.mentalhealth.org.uk/ explore-mental-health/mental-health-statistics/stressstatistics
Stylios, G. K., & Chen, M. (2016). Theta Power - An overview. ScienceDirect Topics. https://www.sciencedirect.com/ topics/engineering/theta-power
The Psychological Effect of Stress on Performance and Learning Memory 53
How does Anorexia Impact the Brain?
 by Alanna Hattori
by Alanna Hattori
Did you know that eating disorders impact at least 9% of the worldwide population or that there are over 2,600 deaths each year due to the eating disorder anorexia nervosa (Eating Recovery Center)? This eating disorder is defined as the fear of gaining weight or having a warped perception of weight. This harmful eating disorder distorts your view of food and can even completely change the structure of your brain. To begin, how exactly does anorexia impact the relationship
SCIENCE
Photo by Hayley Murray on Unsplash
between food and the brain?

In a study, researchers wanted to document how changes in reward responses change food intake control circuitry. In this experiment, participants either received or were denied a random sugar stimulus. The researchers wanted to examine the brain's reward response, also known as a prediction error, which is a "dopamine-related signaling process that measures the degree of deviation from expectation, or how surprised a person was to receive the unexpected stimulus. A higher prediction error indicates that the person was more surprised, while a lower prediction error indicates they were less surprised”(National Institute of Health, 2012). The group of people without eating disorders showed no clear correlation between reward response, BMI(body mass index), and eating disorder behavior. The ventral striatalhypothalamic connectivity in the brain (receiving stimuli) was different in the group with eating disorders. Unlike test subjects without an eating disorder history, where the connectivity from the ventral striatum went straight to the hypothalamus (National Institute of Health, 2012), it was the opposite direction in the group with eating disorders. This could explain why they have trouble with hunger cues, feel out of control, and more, as the hypothalamus controls these signals. When the hypothalamus doesn't receive the stimulus from the ventral striatalhypothalamic connectivity, it makes it easier for people with eating disorders to ignore these hunger cues and persist in their cycle of starvation. This highlights
a higher prediction error response in the brains of people with restrictive eating disorders like anorexia, making it easier to resist food cravings, leading to a more restrictive food intake and perpetuating the cycle of unhealthy eating.
Anorexia can also change the structure of the brain itself. For example, according to Esther Walton,
How does Anorexia Impact the Brain?
55
Photo by Quin Stevenson on Unsplash
(England, 2022). This helps to show us that Starvation can cause damage to key neurons in the brain and result in decreased gray matter, leading to problems such as decreased fine motor skills (Evans, 2021). Gray matter is crucial for memory, decision-making, and emotions, and a decrease can have severe consequences (Bushak, 2020). Anorexia can also shrink the brain in three areas: cortical thickness, subcortical volumes, and cortical surface area, which is significant and indicates a loss of brain cells and connections between them (Science Daily). In conclusion, anorexia can have damaging effects on the brain structure, causing a decrease in gray matter and shrinkage in brain size.
Due to the impacts on the brain, anorexia is proven to be very dangerous. However, there are ways to help prevent long-term brain damage or changes. For example, researchers have found that early treatment for anorexia can help minimize the damage. Christian Buckley has even stated that
(England, 2021). A study revealed that patients who were in recovery from anorexia showed lesser reductions in brain structure compared to those still struggling with the condition (England, 2021). These changes in the brain are not permanent and can be partially reversed with appropriate treatment. Another study focused on women undergoing long-term recovery found that the brain can heal itself over time after recovery, with little difference observed between women with a history of anorexia and those without (England, 2021). Both of these studies suggest that although full reversal of brain damage may not be possible, recovery can significantly reduce it.
In conclusion, the condition of anorexia can profoundly impact the brain and its structure, as evidenced by the potential loss of gray matter and the reduction in the size and function of the brain. However, despite these challenging effects, it is important to remain hopeful and understand that, with the appropriate care and treatment, some of these changes may be partially reversed.
"Prolonged starvation can also lead to neurons in the brain being broken down in order to preserve other specific aspects of the brain, which can decrease the gray matter volume”
"early intervention for anorexia is key to the safest and fastest recovery"
56 SPECTRUM VOL.3 SCIENCE
References
Anorexia Can Actually Change Brain Structure. (2023). Retrieved 3 February 2023, from https://www.verywellmind. com/news-anorexia-can-actually-change-brainstructure-5441589
Anorexia nervosa - Symptoms and causes. (2023). Retrieved 3 February 2023, from https://www.mayoclinic.org/diseasesconditions/anorexia-nervosa/symptoms-causes/syc20353591
Anorexia Nervosa Treatment & Recovery Centers | Eating Recovery Center. (2023). Retrieved 3 February 2023, from https://www.eatingrecoverycenter.com/con
How Malnourishment Affects the Brain: Research on Anorexia and Neurobiology. (2023). Retrieved 3 February 2023, from https://www.eatingdisorderhope.com/ information/anorexia/how-malnourishment-affects-thebrain-research-on-an
“Large Study Reveals Stark Changes in Brain Structure for People with Anorexia.” ScienceDaily, ScienceDaily, 7 June 2022, https://www.sciencedaily.com/ releases/2022/06/220607120952.htm#:~:text=They%20 reveal%20that%20people%20with,or%20the%20 connections%20between%20them.
Parmet, S. (2023). Abnormalities found in ‘insight’ areas of the brain in anorexia | UIC Today. Retrieved 3 February 2023, from https://today.uic.edu/abnormalities-found-in-insightareas-of-the-brain-in-anorexia/
57
How does Anorexia Impact the Brain
How Does The Sun Keep Shining?
 by Nikita Chanda
by Nikita Chanda
SCIENCE SPECTRUM SCIENCE
Photo by NASA on Unsplash
Likea little boy stealing bread from the grocery store, I am just trying to survive. Everyday, I face a battle within me. It is so tiring. Inside me, protons infest my body. The heat of my existence rips them apart from their homes, their nucleus. My maternal instinct to bring them together again overcomes me and my will to live. I am incapacitated by the lethal chokehold which is my inability to fix this. A being named Coulomb forces my protons apart from each other when they get too close. It hurts so much I wish I could make it disappear, but no matter how many times I search, Coulomb is invisible to the naked eye.
I have made futile attempts to force my protons together to find peace. I had come to the realization that the pressure from my stress allows protons to be near each other, so I put myself under extreme pressure to fulfill this goal. Alas, the protons would never stay in the same home. But in spite of that, I was able to seek refuge. There is this magical property within me that I have observed. You see, Coulomb, or the repulsion between my protons, creates a barrier that prevents them from being together– but by a miracle, my protons can tunnel through those barriers.
One may wonder, how does this let me shine? Shine, I feel, is a terrible choice of word. I don’t shine. I flame. I ignite with anger, with heat, because all my efforts
are for naught. As it turns out, when my protons come together they don’t come together. They fuse. Their fusion blazes an eternal fire inside of me that I can never escape from. Shine? No. My “shine” is simply excessive amounts of energy in the form of heat and light. I am a smoldering entity struggling to endure the blazing fire kindling inside of me.
Quantum Tunneling in the Sun
The quantum mechanical phenomenon of protons tunneling through barriers to fuse together is called quantum tunneling.
Imagine dropping a ball down a curved hill. The ball goes down and up the hill, but then drops to its initial position. It doesn’t go over the top because you didn’t give it enough energy to do so. How can you make it go to the other side? Give it more energy. But, what if you can’t? Enter in: quantum mechanics. In the quantum realm, that ball can tunnel through the hill (Libretexts).

How does The Sun Keep Shining? 59
In quantum mechanics, a particle is described using a wavefunction, which tells us the particle’s momentum and position. A wavefunction squared gives the probability of a particle being at a given position during a given time, or its probability distribution (Orzel).

Due to the Heisenberg Uncertainty Principle, there is always some level of uncertainty as to where a particle is. This means that there is never a probability of 0 or 1. So, if we come across a barrier where it is virtually impossible for the particle to exist, the particle’s probability distribution rapidly decreases toward zero– meaning, there may be an extremely low probability, but it is still possible (Orzel).
What does this mean? Consider two positively-charged particles that would normally repel each other because of Coulomb’s force (Ash). In this case, the forbidden region where the proton’s wavefunction decreases exponentially is when the proton gets close to another
proton, and the other side of this barrier shows the probability of them fusing together (Orzel). Like tunneling through a hill, the protons in the sun can essentially teleport to being fused together.
The probability distribution of a particle coming in from the left, hitting a barrier where the potential energy of the particle would increase above the total energy of the particle. The probability drops off rapidly in this region but does not reach zero, so there is a probability of seeing the particle to the right of the barrier. If it did tunnel, it would have the exact same amount of energy as it did to the left of the barrier (Orzel).
Now, it is clear how quantum tunneling exists inside the sun. But why do these protons have to fuse?
The sun is fueled by nuclear reactions that fuse H+ atoms together into heli-
“Fusion is not like bonding; it is the process of converting one element into another by changing an atom’s number of protons, releasing extreme amounts of energy. This phenomenon only occurs in environments with gigantic temperatures and pressures– like in the center of a star (Ash).”
60 SPECTRUM VOL.3 SCIENCE
When these protons fuse, one of them releases a positron(e+) and a neutrino(Ve), allowing the proton to act like a neutron. This creates an isotope of hydrogen, called deuterium. The deuterium nuclei then either merge to form helium nuclei or link with other protons to create another helium isotope (Ash). From here, these helium nuclei can fuse to make a beryllium isotope. Finally, the beryllium isotope releases two of its protons, resulting in helium. At each step of the way, huge amounts of energy are released in the form of both heat and sunlight (Ash).

This is what makes the sun, our source of life, shine.
References
Orzel, Chad. How to Teach Quantum Physics to Your Dog. Scribner, 2010.
Ash, Arvin. “Why Does the Sun Shine? The Quantum Explanation for How the Sun Works”. YouTube, 17 Apr. 2021, https://www. youtube.com/watch?v=xR88vSiOvY4.
The Heisenberg Uncertainty Principle

It is impossible to know both the position and momentum of a particle. Essentially, unlike the classical world we’re used to, the quantum realm is probabilistic as there will always be some level of uncertainty.
Libretexts. “4.9: Quantum-Mechanical Tunneling.” Chemistry LibreTexts, Libretexts, 17 July 2020, https://chem.libretexts. org/Courses/University_of_California_Davis/UCD_Chem_1 07B%3A_Physical_Chemistry_for_Life_Scientists/Chapters/4%3A_Quantum_Theory/4.09%3A_Quantum-Mechanical_Tunneling.
How does The Sun Keep Shining? 61
TECHNOLOGY& ENGINEERING

An Introduction to Lethal Autonomous Weapons Systems (LAWS) Vyjayanti Vasudevan ChatGPT Article Chan Park 64 68 Control Systems in Robotics Marcus Chin 72

An Introduction to Lethal Autonomous Weapons Systems (LAWS)
 by Vyjayanti Vasudevan
by Vyjayanti Vasudevan
As we move into the future, many are beginning to question whether technology will replace the role of humans in wielding weaponry. Defense systems have always played a significant role in national security, dating back to 2200 BCE when the Egyptians’ use of Ancient Naval Weapons helped guard the Nile and secure a steady source of seafood for the citizens (Binnie, 2021). However, efficient mechanized defense systems were implemented only after the Industrial Revolution. Despite the initial naive curiosity towards mass industrial production, manufacturing lethal weapons would lead to one of the
deadliest wars in history: WW1. From grenades to tanks, nations have the world at their command in their production of artillery. In recent decades, with the rapid growth of Artificial Intelligence, Lethal Autonomous Weapons Systems (LAWS) are predicted to carve the way for future national security and military operations. However, modern weaponry may be more out of human influence with these LAWS.
LAWS are programmed military systems that can function autonomously with remote human control. The functioning of such systems is mainly dependent
TECHNOLOGY
Photo by Jon Tyson on Unsplash
64 VOL.2 SPECTRUM 64 VOL.3
Photo by NASA on Unsplash
to Lethal Autonomous Weapons Systems (LAWS) on communications and algorithms that filter through data from navigating systems, sensors, et cetera to achieve a certain goal like blocking a missile or bombing a target. Nations such as South Korea, as early as the 1990s, purchased air vehicles designed to defend and attack particular targets. The main concern with such systems today is their reliance on accurate data. Without the conscience and ability of humans to make complex decisions on-demand, algorithms feed off of data to be able to recognize patterns. Without adequate or unbiased data, LAWS can inflict deathly harm, resulting in questions regarding liability in cases of accidental deaths. The ability of such weapons to inflict mass destruction is faster than humans can respond.

The evolving abilities of LAWS can be observed in the Nagorno-Karabakh War during which semi-autonomous drones and air missiles utilized by Azerbaijan, as
well as Israel’s unmanned Suicide drones, defeated Russian missiles. This ultimately secured Azerbaijan’s victory over Armenian forces in the war. This was only made possible because Azerbaijan’s access to better resources resulted in their superior weapons technology, increasing society’s emphasis on advancing the tech field. From surveillance drones to security processing by the Department of Defense, it’s clear that with such increasing dependence on technology comes an apparent power asymmetry that plays a decisive role in national security. Any altercations between USA and Taiwan or USA and China, given their reliance on the semiconductor industry in Taiwan, give Taiwan a military advantage. According to Noel Sharkey, a robotics professor at the University of Sheffield in England, nations ignorant of the regulations of LAWS have “a blinkered view that prevents them from considering the disturbing scenarios
An Introduction
65 65
Photo by Don Jackson Wyatt on Unsplash
that can unfold when rivals catch up” (Scientific American, 2020). In other words, the impacts of such weapons are unstable and unpredictable regarding the future hierarchy of larger military powers. While Taiwan might remain the “underdog” in the power struggle with China,

as nations become more reliant on their large semiconductor, cybersecurity, and software manufacturing capabilities, roles could reverse in the future.
Whether or not fully lethal automated weapons remain merely a figment of our imagination, neglecting their rapid development when creating future military regulations. Amidst the uncertainty surrounding LAWS, one thing remains clear—

TECHNOLOGY
it’s of the essence that nations must decide now the path they want to take when it comes to addressing restrictions behind their production and utility in national security.
Photo by Peter Garguilo on Unsplash
66 VOL.2 SPECTRUM 66 VOL.3
Photo by RichardrShune on Unsplash
An Introduction to Lethal Autonomous Weapons Systems
References
Mapson, G. (2021). Sea mines: the asymmetrical weapon Australia must have | The Strategist. Retrieved 27 January 2023, from https://www.aspistrategist.org.au/sea-minesthe-asymmetrical-weapon-australia-must-have/
Sharkey, N. (2023). Fully Autonomous Weapons Pose Unique Dangers to Humankind. Retrieved 27 January 2023, from https://www.scientificamerican.com/article/ fully-autonomous-weapons-pose-unique-dangers-tohumankind/
Christ, K. (2021). Swords and Shields: Autonomy, AI, and the Offense-Defense Balance - Georgetown Journal of International Affairs. Retrieved 27 January 2023, from https:// gjia.georgetown.edu/2021/11/22/swords-and-shieldsautonomy-ai-and-the-offense-defense-balance/
Shivakumar, S., & Wessner, C. (2022). Semiconductors and National Defense: What Are the Stakes?. Retrieved 28 January 2023, from https://www.csis.org/analysis/ semiconductors-and-national-defense-what-are-stakes Pandya, J. (2023). The Weaponization Of Artificial Intelligence. Retrieved 28 January 2023, from https://www.forbes.com/ sites/cognitiveworld/2019/01/14/the-weaponization-ofartificial-intelligence/?sh=542d412c3686

(LAWS)
67
Photo by UX Gun on Unsplash
by Chan Park
ChatGPT
ChatGPT is a language model developed by OpenAI that is designed to generate human-like text. It is based on the transformer network architecture and is fine-tuned on a massive dataset of internet text to handle conversational language. The model has many benefits, including its ability to handle out-of-vocabulary words, generate coherent text, and be finetuned for specific tasks. However, there are also risks associated with the model, including the potential for the generation of biased or misleading text and the potential for the model to be used for malicious purposes.
Did you know that eating disorders impact at least 9% of the worldwide population or that there are over 2,600 deaths each year due to the eating disorder anorexia nervosa (Eating Recovery Center)? This eating disorder is defined as the fear of gaining weight or having a warped perception of weight. This harmful eating disorder distorts your view of food and can even completely change the structure of your brain. To begin, how exactly does anorexia impact the relationship
The origin of ChatGPT can be traced back to the development of GPT (Generative Pre-trained Transformer) by OpenAI in 2018. Over the years, OpenAI has developed larger models with more advanced capabilities, such as GPT-2 and GPT-3, which have been fine-tuned for specific tasks. ChatGPT is the latest version of GPT-3, fine-tuned specifically for conversational language. One of the main benefits of ChatGPT is its ability to generate human-like text. This makes it useful for a wide range of natural language processing tasks, such as language translation, text
 Photo by Hayley Murray on Unsplash
Photo by Hayley Murray on Unsplash
68 VOL.3 SPECTRUM TECHNOLOGY
Photo by Zac Wolff on Unsplash
summarization, and question answering. The model's ability to handle out-ofvocabulary words and generate coherent text also makes it useful for text-based applications such as chatbots and virtual assistants.
However, there are also risks associated with ChatGPT. One of the main risks is the potential for the model to generate biased or misleading text. This is because the model is trained on a massive dataset of internet text, which may contain biases and inaccuracies. This can lead to the generation of biased or misleading text, which can have negative consequences for individuals and society. Another risk associated with ChatGPT is the potential for the model to be used
for malicious purposes. The model's ability to generate human-like text can be used to create fake news or impersonate individuals online. This can lead to the spread of misinformation and the erosion of trust in online communication.
In conclusion, ChatGPT is a powerful language model with many benefits, including its ability to generate humanlike text and be fine-tuned for specific tasks. However, it is important to consider the potential risks associated with the model, including the potential for biased or misleading text and malicious use, and take steps to mitigate them. OpenAI encourages its users to use the model responsibly and report any misuse of the model.
Would you believe me if I told you that an AI wrote this? I wouldn’t; quite frankly, I still don’t believe it. ChatGPT, ever since it has been dropped, has been a hot topic for people, including my teachers, friends, and parents. So, I tried it, and here is what I asked it to do:
The response to my directions from ChatGPT, surprisingly, was the first 300 words that you have read of this writing. Well, that’s my piece right there! Thanks ChatGPT! I don’t have to do any work! Yahoo! Of course, I am not going to just copy and paste the whole response as the final draft of this piece. I am not that lazy. (Hmm… Is that true, though?)
Anyways, one thing for sure is that you
can’t tell immediately that a robot wrote this. Most of the time, especially if you played around with chatbots such as Eliza, AIs give us a response that contains awkward word choices or sentence structures that make you squint while reading. But ChatGPT, it seems like, doesn’t have any of those obvious signs that throw the reader off like the past chatbot or natural language processing models did. The chatbot’s writing seems
ChatGPT
Photo by Quin Stevenson on Unsplash
69 69
eerily similar to what a normal human would write. Because of this uncanniness, some teachers are panicking and are having emergency meetings, afraid that their students will use ChatGPT to cheat on their assignments.
However, I think otherwise; I believe the benefits of ChatGPT outweigh its risks in educational contexts.
Firstly, ChatGPT can be a teacher’s best tool. For example, Cherie Shields, a high school English teacher in Oregon, had recently assigned students in one of her classes to use ChatGPT to create outlines for their essays comparing and contrasting two 19th-century short stories that touch on themes of gender and mental health: “The Story of an Hour,” by Kate Chopin, and “The Yellow Wallpaper,” by Charlotte Perkins Gilman. Once the outlines were generated, her students put their laptops away and wrote their essays longhand (Roose). Such activity involves a lot of thinking for the students as they need to assess which information they should synthesize based on the generated outlines and examine the overall structure of the essay to make sure the essay flow is coherent throughout. Even ChatGPT’s flaws— such that its answers may be biased or factually wrong— can stimulate critical thinking among students to rethink about ChatGPT’s answers and make necessary changes.
ChatGPT can also help teachers save time preparing for class. Jon Gold, an eighth-grade history teacher at Moses Brown School, a pre-K through twelveth-
grade Quaker school in Providence, R.I., said that he had experimented with using ChatGPT to generate quizzes (Roose). He fed the bot an article about Ukraine, for example, and asked it to generate 10 multiple-choice questions that could be used to test students’ understanding of the article.
Did you know that eating disorders impact at least 9% of the worldwide population or that there are over 2,600 deaths each year due to the eating disorder anorexia nervosa (Eating Recovery Center)? This eating disorder is defined as the fear of gaining weight or having a warped perception of weight. This harmful eating disorder distorts your view of food and can even completely change the structure of your brain. To begin, how exactly does anorexia impact the relationship
It is almost inevitable that tools like ChatGPT will only improve and become an inseparable piece in our society. Then, rather than viewing this sudden shift in technology as a disastrous apocalypse, we should embrace it, and learn how to use them. The adjustments won’t be easy, but

TECHNOLOGY
Photo by Hayley Murray on Unsplash
70 VOL.2 SPECTRUM 70 VOL.3
Photo by Mojahid Mottaki on Unsplash
who else but the teachers would guide us through this?
References
Roose, K. (2023, January 12). Don't ban chatgpt in schools. teach with it. The New York Times. Retrieved February 5, 2023, from https://www.nytimes.com/2023/01/12/technology/ chatgpt-schools-teachers.html

ChatGPT
71
Control Systems in Robotics
 by Marcus Chin
by Marcus Chin
Kinematics equations are often used to represent ideal situations that only exist within textbooks. While they provide an adequate basis to approach real-world problems, this doesn’t work in robotics. There are too many factors to consider, even when doing something as simple as driving forward one meter. Chances are, the robot will overshoot its target, slide a bit to the left or right, or maybe even tip over. Because of this, programmers and engineers need to apply control systems to robotics in order
to provide more precise and smooth movement to robot systems. The field of control theory incorporates advanced mathematics that can be difficult to understand, but Proportional Integral Derivative (PID), the most common control system applied to robotics, can be explained in basic terms. PID describes the different terms used to calculate output based on a specified setpoint and its current position, also known as the error (relative to the setpoint). For example, if a robot is at
Engineering 72 VOL.2 SPECTRUM 72 VOL.3
Photo by nandito f on Unsplash
position 0 and wants to move to position 10, we could accomplish this by using a PID control system, we would specify the setpoint to be position 10, and the error
that the control system identifies would be 10 units since it is 10 units away from the setpoint.
PID Control (Photo by Technology Robotix Society on Medium)
The main term that makes PID “work” is the proportional term. It is defined by the formula kP * ERROR, where kP is a constant. A proportional controller would use this formula to give the output of the system to reach the setpoint. The reason why the proportional controller works is that the error of a system will decrease as the controller runs. If the system runs for one second, the error decreases since the proportional term will specify an output that moves the system closer to its setpoint. Since the error decreases, the output also decreases, and this continues until the system slowly approaches its setpoint. Put plainly, the proportional

controller makes a robot faster if it is further away from where it wants to go and vice versa. However, a proportional controller will only be effective if it is tuned correctly, meaning a correct constant value for kP is selected. This value will differ based on the system. If kP is too high, the output will overshoot the setpoint and may result in an infinite oscillation. Consequently, if kP is too low, the output will undershoot and never reach the setpoint. When a correct value for kP is found, the system should stabilize at its setpoint without oscillations.
The integral and derivative terms of PID controllers are slightly more complex and use calculus, but they are
Control Systems in Robotics 73
still somewhat intuitive. Both these terms are added to the proportional term to generate the full equation, Output = Proportional + Integral + Derivative. Since I and D are mostly used to further refine the proportional term, they are relatively insignificant compared to the proportional term and are not always used. Standalone integral controllers are only used in niche situations, and standalone derivative controllers don’t work as they cannot identify a setpoint. Nevertheless, depending on the application, they can help to make PID controllers more smooth and more accurate.
The integral term is defined by kI * Integral(ERROR). All this term does is accentuate the output the further away the system is from the setpoint, reducing the steady-state error of the system, which is the difference between the ending state and setpoint (The PID Controller & Theory Explained, n.d.). It essentially “accumulates” the error, which you can visualize as the area under the error (position) graph, also known as the absement. Like the proportional term, the magnitude of the integral term can be accentuated by the kI constant. However, adding an integral term incorrectly can have adverse effects, including violent overshooting.
Lastly, the derivative term is defined by kD * dERROR/dt. The effect of the derivative term is that it scales with the slope of the error graph, essentially attempting to linearize it. This can remove a lot of overshooting and oscillation, but it is commonly not used due to instability when used in practical applications. It also can significantly
reduce the response time of a controller due to the calculations for the derivative term being more complex (Libretexts, 2022).
When control systems come together, a robot can be programmed to be seamlessly smooth. Most robots in robotics competitions use some sort of PID control, whether that be for autonomous driving or arm control. Some even use more advanced control systems, such as Linear Quadratic Regulator (LQR) control which utilizes linear algebra to create a state-space control system that is more advanced and effective than PID for some use cases like auto-balancing. While the end product may seem to work seamlessly, understanding the complex theory behind robotics provides insight into how mathematical models are applied in the real world.
Engineering 74 VOL.2 SPECTRUM 74 VOL.3
Drones use control systems like LQR controllers to stabilize their position

References
Libretexts. (2022, May 22). 9.2: P, I, D, PI, PD, and PID control. Engineering LibreTexts. https://eng.libretexts.org/ Bookshelves/Industrial_and_Systems_Engineering/Book:_ Chemical_Process_Dynamics_and_Controls_(Woolf)/09:_ Proportional-Integral-Derivative_(PID)_Control/9.02:_P,_I,_ D,_PI,_PD,_and_PID_control
The PID Controller & Theory Explained. (n.d.). NI. https://www. ni.com/en-sg/innovations/white-papers/06/pid-theoryexplained.html
(Photo by Alessio Soggetti on Unsplash)
Control Systems in Robotics 75

Community Introducing the Spectrum STEM Mentorship Program Jessica Kang 78 Gyulim Jessica Kang

77
Introducing the Spectrum STEM Mentorship Program
 By Gyulim Jessica Kang
By Gyulim Jessica Kang
COMMUNITY
Photo by Brooke Cagle on Unsplash
The Spectrum Outreach team, in collaboration with members of Spectrum, is proud to announce a new STEM mentoring program aimed at inspiring the next generation of young scientists and engineers.
Theprogram will take place bi-weekly and is designed to teach fifth graders about different STEM subjects, such as Earth Day and DNA Day. But this isn't your average program - it goes beyond lectures and worksheets.

Instead, the program encourages creativity in STEM by allowing students to choose their own projects. They can create a drawing, a sculpture, or anything else that inspires them. The Spectrum team will provide feedback on their projects during the second session of the month, and the best works will be featured on the Spectrum website.
Through this program, fifth graders will learn about different aspects of STEM and develop valuable skills like research and scientific writing. By exploring their interests and creativity in STEM, they may discover new passions and even consider a career in the field.
During the first session of the program, the Spectrum Outreach team taught the students about pi, the mathematical constant that represents the ratio of a circle's circumference to its diameter. The students were fascinated by the concept and eager to learn more about how it relates to the world around them.
Introducing the Spectrum STEM Mentorship Program
79
We were thrilled to see their enthusiasm and excitement for STEM!
Below, you can see the students eagerly participating in the lesson, working together on their projects, and having fun while learning about pi.
The Spectrum Outreach team's STEM mentoring program is an excellent opportunity for fifth graders to learn and explore the exciting world of STEM. By fostering creativity and curiosity, this

program provides a unique and engaging approach to learning that goes beyond textbooks and lectures.
We hope this program can help the students develop valuable skills and discover new passions.
COMMUNITY
80 VOL.2 SPECTRUM 80 VOL.3
Who knows, they may even go on to make groundbreaking discoveries and innovations that will shape our world for years to come.
Join us in supporting the Spectrum Outreach team's STEM mentoring program and help inspire the next generation of STEM leaders!
Introducing the Spectrum STEM Mentorship Program 81


VOL.3 2023 MAY www.spectrumsas.org








 By Gyulim Jessica Kang
By Gyulim Jessica Kang




 By Sophia Reiner
Photo by Giulia May on Unsplash
By Sophia Reiner
Photo by Giulia May on Unsplash





 by Akshay Agarwal
Photo by Luis Villasmil on Unsplash
by Akshay Agarwal
Photo by Luis Villasmil on Unsplash

 Game Theory
Game Theory









 Glia: The Lesser Known Brain Cells
Glia: The Lesser Known Brain Cells

by
by




 by Morgan Ahn
by Morgan Ahn






 by Anna Hyunjin Choi
Photo by Luis Villasmil on Unsplash
by Anna Hyunjin Choi
Photo by Luis Villasmil on Unsplash





 by Alanna Hattori
by Alanna Hattori

 by Nikita Chanda
by Nikita Chanda






 by Vyjayanti Vasudevan
by Vyjayanti Vasudevan




 Photo by Hayley Murray on Unsplash
Photo by Hayley Murray on Unsplash


 by Marcus Chin
by Marcus Chin




 By Gyulim Jessica Kang
By Gyulim Jessica Kang



